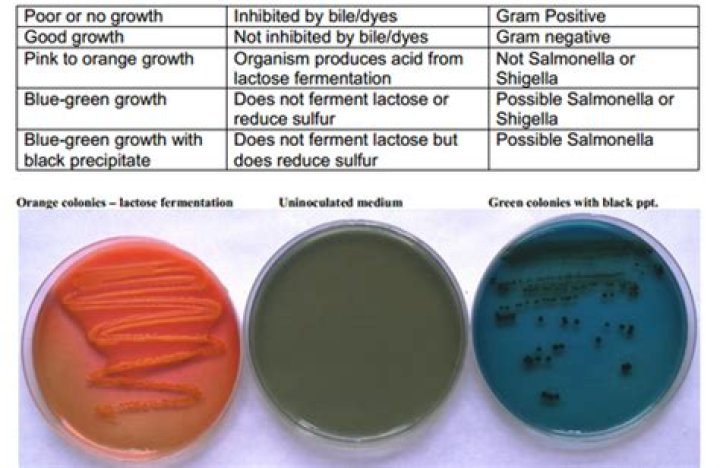

Which of the selective/enriched/differential agar(s) inhibit gram-positive growth?
The selective agent in MacConkey agar that inhibits the growth of gram-positive organisms is the crystal violet and bile salts.
Which medium is used to inhibit the growth of Gram positive organisms?
An example of a selective medium is MacConkey agar. It contains bile salts and crystal violet, which interfere with the growth of many gram-positive bacteria and favor the growth of gram-negative bacteria, particularly the Enterobacteriaceae.
Which component in EMB agar inhibit the growth of Gram-positive bacteria?
EMB contains the dyes eosin and methylene blue that inhibit the growth of gram-positve bacteria.
What agar is selective for Gram-positive bacteria?
Mannitol salt agar (MSA) which is selective for Gram-positive bacteria and differential for mannitol.
Which medium is both selective and differential and contains dyes that inhibit the growth of Gram-positive bacteria?
MacConkey Agar. This medium is both selective and differential. The selective ingredients are the bile salts and the dye, crystal violet which inhibit the growth of Gram-positive bacteria.
Enriched, Selective, and Differential Media
38 related questions foundWhich of the following inhibits the growth of Gram positive bacteria?
The lauric acid used acts as an activated component that selectively inhibits gram-positive bacteria. Lauric acid as a free fatty acid can only infiltrate into the bacterium cell to a limited extent.
Why MacConkey agar and mannitol salt agar MSA are regarded as selective and differential medium?
Mannitol Salt Agar (MSA) is a selective and differential medium. The high concentration of salt (7.5%) selects for members of the genus Staphylococcus, since they can tolerate high saline levels. Organisms from other genera may grow, but they typically grow very weakly.
Which medium inhibits the growth of Gram positive bacteria quizlet?
The selective agent in MacConkey agar that inhibits the growth of gram-positive organisms is the crystal violet and bile salts.
Is Mueller Hinton agar selective or differential media?
Mueller-Hinton has a few properties that make it excellent for antibiotic use. First of all, it is a non-selective, non-differential medium. This means that almost all organisms plated on here will grow. Additionally, it contains starch.
Is MacConkey agar selective is it differential?
MacConkey agar is an example of a medium that is both differential and selective. The presence of bile salts, as well as crystal violet, within the media prevent gram-positive organisms from growing. ... aeruginosa since it is a lactose fermenter on MacConkey agar.
How does EMB agar inhibit gram positive?
Eosin and methylene blue act as indicators to differentiate between Gram negative organisms that ferment lactose and those that do not ferment lactose. ... The growth of Gram positive bacteria is generally inhibited on EMB agar because of the toxicity of methlyene blue dye.
Are EMB plates selective or differential?
Eosin methylene blue agar (EMB) is a selective and differential medium used to isolate fecal coliforms. Eosin Y and methylene blue are pH indicator dyes which combine to form a dark purple precipitate at low pH; they also serve to inhibit the growth of most Gram positive organisms.
Is EMB selective or differential quizlet?
-Eosin Methylene Blue (EMB) agar is a complex (chemically undefined), moderately selective, and differential medium. -Eosin Methylene Blue (EMB) agar are selective for Gram-negative organisms and contain indicators to differentiate lactose fermenters from lactose non-fermenters.
What is differential medium?
Differential medium. a medium which is used to differentiate different types of microorganisms based on their different colours or colony shapes. Examples of differential media are: Macconkey's agar and SS agar.
Is hektoen enteric agar selective or differential?
BD Hektoen Enteric Agar is a moderately selective and differential medium for the isolation and cultivation of gram-negative enteric micro-organisms, especially for the isolation of Shigella and Salmonella species from fecal specimens.
What is non selective medium?
[¦nän·si‚lek·tiv ′mē·dē·əm] (microbiology) A culture medium that supports the growth of all genotypes.
How does MacConkey agar selective for gram negative?
MacConkey agar is used for the isolation of gram-negative enteric bacteria and the differentiation of lactose fermenting from lactose non-fermenting gram-negative bacteria. ... The selective action of this medium is attributed to crystal violet and bile salts, which are inhibitory to most species of gram-positive bacteria.
Is mannitol salt agar a differential or selective medium?
This type of medium is both selective and differential. This is in contrast to Streptococcus species, whose growth is selected against by this high salt agar (plate on the right in the picture below). ...
Why is Mueller-Hinton agar MHA used for the disk diffusion method or Kirby-Bauer test )?
The media used in this test has to be the Mueller-Hinton (15x150mm) agar because it is an agar that is thoroughly tested for its composition and its pH level. Also, using this agar ensures that zones of inhibitions can be reproduced from the same organism, and this agar does not inhibit sulfonamides.
Which of the following inhibits the growth of Gram-negative bacteria?
From gram-negative bacteria like P. aeruginosa and E. coli, the selenium coated paper towels also significantly inhibited bacterial growth after either 48 or 72 hours of incubation.
Which of the following inhibits the growth of Gram-negative bacteria quizlet?
PEA agar inhibits the growth of Gram-negative bacteria, but not Gram-positive bacteria.
How is MSA selective and differential quizlet?
MSA is both a Selective and a Differential Media. How is MSA a selective media? MSA contains a high salt concentration and only organisms that can grow in a high salinity environment can grow in this media. Most selective for Staphylococci.
Why is MacConkey agar selective as well as differential?
Why is MacConkey agar selective as well as differential? It's selective to gram negative enteric bacteria because it contains bile salts, which inhibit most gram positive bacteria. It also contains lactose, which differentiates between gram negative lactose fermenter and gram negative non-fermenters.
Why is mannitol salt agar both selective and differential?
Mannitol Salt Agar (MSA) is both selective and differential. It contains 7.5% sodium chloride which selects for organisms that are halotolerant. It also contains the carbohydrate mannitol, and a pH indicator, phenol red, which allow distinction between organisms which can ferment mannitol and those that can not.
What is the selective agent found in MSA?
Mannitol Salt Agar (MSA)
This is a medium that is both selective and differential. The high salt concentration (7.5%) is the selective ingredient. Staphylococcus species, which commonly inhabit human skin, can grow on this high salt concentration (left plate in picture below).



